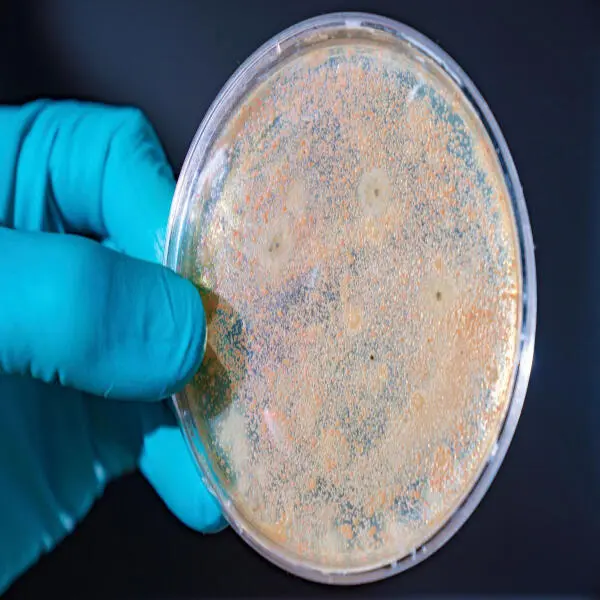
Mật độ vi khuẩn cao trong ao nuôi: Mối nguy hiểm tiềm ẩn đối với tôm

Tôm Càng Xanh Giống Đực: Lợi Ích và Thách Thức Trong Nuôi Trồng Tôm càng xanh (Macrobrachium rosenbergii) là một loài tôm nuôi quan trọng trong ngành thủy sản, được nuôi rộng rãi tại nhiều quốc gia ...
Giảm Ô Nhiễm, Tăng Hiệu Quả: Giải Pháp Mới Cho Ngành Nuôi Tôm Ngành nuôi tôm đóng vai trò quan trọng trong phát triển kinh tế và xuất khẩu thủy sản của Việt Nam. Tuy nhiên, sự phát triển nhanh chóng ...
Mật độ vi khuẩn cao trong ao nuôi: Mối nguy hiểm tiềm ẩn đối với tôm Trong nuôi trồng thủy sản, đặc biệt là nuôi tôm, vi khuẩn đóng vai trò quan trọng trong hệ sinh thái ao nuôi. Tuy nhiên, khi mật ...
Tối Ưu Hóa Hiệu Quả Nuôi Tôm: Giải Pháp Toàn Diện Cho Năng Suất Vượt Trội Ngành nuôi tôm đóng vai trò quan trọng trong nền kinh tế thủy sản, nhưng đối mặt với nhiều thách thức như dịch bệnh, ô nhiễm ...
EHP Ở Tôm: Cách Vi Bào Tử Trùng Phá Hệ Thống Tiêu Hóa Và Giảm Tăng Trưởng 1. EHP và mối đe dọa đối với tôm Enterocytozoon hepatopenaei (EHP) là một loại vi bào tử trùng ký sinh bên trong tế bào của ...
Chiến lược bán tôm 2025: Thời điểm nào giúp tối đa lợi nhuận? 1. Tổng quan về thị trường tôm năm 2025 Xu hướng tiêu thụ tôm toàn cầu Năm 2025, thị trường tôm thế giới tiếp tục tăng trưởng nhờ nhu cầu ...
Vi Bào Tử Trùng Trong Ao Nuôi Tôm: Nguyên Nhân, Hậu Quả Và Cách Phòng Trị 1. vi bào tử trùng trong ao nuôi tôm Vi bào tử trùng ( Enterocytozoon hepatopenaei - EHP) là một loại vi sinh vật ký sinh ...
Giải Pháp Tăng Kiềm Cho Ao Tôm – Bảo Vệ Sức Khỏe & Tăng Năng Lượng Tiết Kiệm 1. Độ Kiềm Trong Ao Nuôi Tôm Độ Kiềm Là Gì? Độ kiềm (đơn vị mg/L hoặc ppm) là khả năng trung hòa axit trong nước, chủ ...
Giải pháp xử lý nước ao lắng hiệu quả – Tiết kiệm chi phí tối đa 1. ao lắng trong nuôi trồng thủy sản Ao lắng đóng vai trò quan trọng trong hệ thống nuôi trồng thủy sản, giúp cải thiện chất lượng ...
Tác Hại Khó Lường Của Độ Đục Nước Trong Ao Nuôi Thủy Sản Trong nuôi trồng thủy sản, độ đục của nước ao nuôi đóng vai trò quan trọng trong việc quyết định sự thành công hay thất bại của mô hình. Độ ...